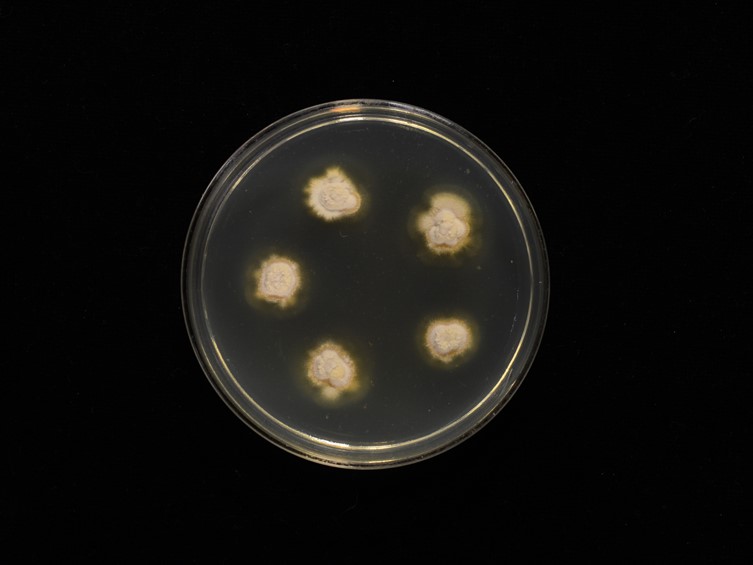

Holotype:
THAILAND, Surat Thani Province, Khao Sok National Park, 14 Oct. 2008, T. Boonpratuang, A. Khonsanit, S. Mongkolsamrit, P. Puyngain, P. Srikitikulchai, K. Tasanathai, holotype BBH 26980, ex-type living culture BCC 34464.
Habitat:
Underside of bamboo leaves.
Host:
Scale insects (Hemiptera).
Description:
 Stromata flat, pale brown, consisting of densely packed hyphae covering an area of 2-2.5 mm diam of undersides of leaves.
Stromata flat, pale brown, consisting of densely packed hyphae covering an area of 2-2.5 mm diam of undersides of leaves.  Synnemata formed on stromata consisting of a weft of hyphae, usually present in groups of 10, up to 1000 μm long, 100 μm wide, pale-brown at the base becoming light brown towards the tip.
Synnemata formed on stromata consisting of a weft of hyphae, usually present in groups of 10, up to 1000 μm long, 100 μm wide, pale-brown at the base becoming light brown towards the tip.  Phialides pear-shaped (hirsutella-like), tapering abruptly into a helical neck, 15-35 μm long, basal part 5-20 × 2-6 μm, attenuated helical neck 6-21 μm long, 1.5 μm wide.
Phialides pear-shaped (hirsutella-like), tapering abruptly into a helical neck, 15-35 μm long, basal part 5-20 × 2-6 μm, attenuated helical neck 6-21 μm long, 1.5 μm wide.  Conidia hyaline, cylindrical, 1- or 2-septate, 9-15 × 3-4 μm.
Conidia hyaline, cylindrical, 1- or 2-septate, 9-15 × 3-4 μm.
Culture characteristics:
Colonies on PDA slow-growing, attaining a diam of 0.5 cm diam in 8 wk at 25 °C, slightly convex, margin uneven, aerial hyphae downy, white to cream-coloured. Phialides subulate, hirsutella-like, formed laterally of hyphae, entire phialides 12–20 × 3–4 μm, helical necks present, hyaline, up to 12.5 μm long. Conidia cylindrical, hyaline, 1-or 2-septate, smooth-walled, 8–15 × 3–4 μm.
Colonies on PDA slow-growing, attaining a diam of 0.5 cm diam in 8 wk at 25 °C, slightly convex, margin uneven, aerial hyphae downy, white to cream-coloured. Phialides subulate, hirsutella-like, formed laterally of hyphae, entire phialides 12–20 × 3–4 μm, helical necks present, hyaline, up to 12.5 μm long. Conidia cylindrical, hyaline, 1-or 2-septate, smooth-walled, 8–15 × 3–4 μm.
Reference:
Luangsa-ard JJ, Mongkolsamrit S, Noisripoom W, et al. (2017). Helicocollum, a new clavicipitalean genus pathogenic to scale insects (Hemiptera) in Thailand. Mycological Progress 16: 419–431.
DOI: https://doi.org/10.1007/s11557-017-1283-3Species |
Strain |
Compound |
Pubchem CID |
Biological activity |
Reference |
|---|
|
Strain |
LSU | TEF1 |
|---|---|---|
| BCC 34463 | KT222328 | KT222326 |
| BCC 34464 | KT222329 | KT222327 |